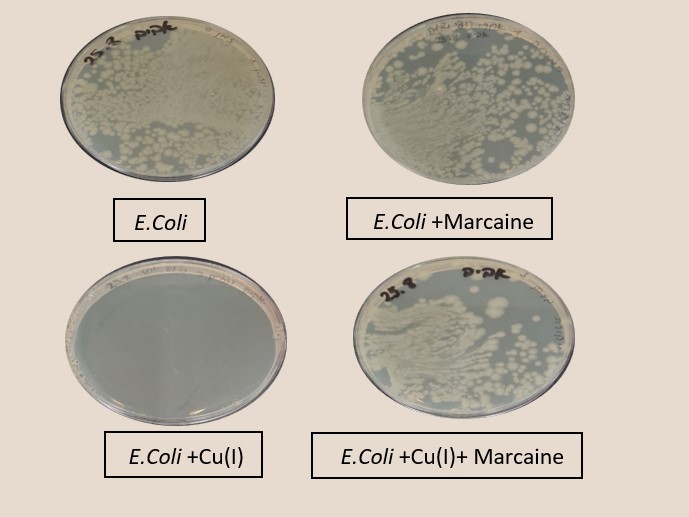
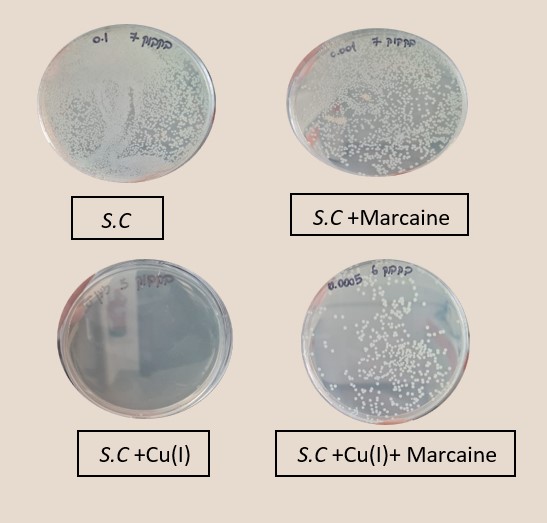

This article attempts to explain the antibacterial mechanism of action of monovalent copper ions.
Recently, studies have shown that Cu+ ions are effective as an antibacterial agent [1,2.3,4]. Cu+ ions can be obtained in a redox reaction of Cu+2 and metallic copper in an oxygen-free atmosphere and in the presence of substances that stabilize Cu+, such as acetonitrile.
This article attempts to explain the antibacterial mechanism of action of monovalent copper ions. When analyzing the results of our research on the subject over the years [1,2.3,4], several points emerge: 1. Fast kinetics, monovalent copper ions reduce the bacterial population by 5 orders of magnitude within a minute. Increasing the temperature increases the effect [2].
We propose a killing mechanism involving the entry of monovalent copper ions into the bacterial Cytoplasm, which causes irreversible enzyme paralysis in the cell.
In the literature, several other hypotheses have been proposed regarding the mechanisms underlying Cu toxicity. A major factor is the ability to act as a catalyst for oxidative damage to tissues through cyclic redox reactions, alternating between Cu+ and Cu2+. The reactive oxygen species (ROS) generated in these reactions directly damage essential cellular components, such as nucleic acids, proteins, and lipids [5, 6, 7]. The significance of the effect of Cu on DNA degradation is still controversial, with different mechanisms of toxicity observed in various types of microorganisms [8]. In several studies that involved enterococci, DNA degradation as a result of the impact of Cu ionic species and further generation of superoxide was recognized as a key factor in the cell death process [9, 10, 11, 12]. In contrast, other studies that explored Cu toxic effect on Gram-negative bacteria such as Escherichia coli and yeasts suggested that depolarization of the cytoplasmic membrane is the main target, and degradation of DNA occurs only after cell death [13,14].
In aqueous solution the common oxidation state of copper ion is divalent (Cu2+, cupric). Copper in a monovalent state (Cu+, cuprous) remains in disproportionately low amounts relative to Cu2+ and metallic copper, since it is unstable and rapidly reacts with molecular oxygen, which oxidizes Cu+ to Cu2+. Nevertheless, it is possible to elevate the amount of Cu+ ions: high concentrations of Cu+ ions in a deaerated aqueous environment may be achieved and maintained by adding reagents, which form a more stable complex with Cu+ than with Cu2+. Acetonitrile [15-16], benzoic acid [17], and ATP [18, 19] are good examples of Cu+ stabilizing reagents, which shift the existing equilibrium between oxidation states toward the formation of two Cu+ ions from one Cu2+ ion and metallic copper.
Lidocaine and Marcaine, class Ib antiarrhythmic agents, are sodium channel blockers. These agents will decrease Vmax in partially depolarized cells with fast response action potentials [21]. Lidocaine and its derivative, benzocaine, block bacterial sodium channels [22].
The effect of monovalent copper ions on enzymatic systems has hardly been studied to date; this is due to the low stability of monovalent copper ions in aqueous solutions, which led to the assumption that their concentration is negligible in biological systems. However, in an anaerobic atmosphere, and in the presence of a ligand that stabilizes the monovalent copper ions over the divalent copper ions, high and stable concentrations of monovalent copper ions can be reached. Moreover, the cell cytoplasm has a substantial concentration of potential stabilizers that can explain significant concentrations of monovalent copper ions in the cytoplasm.
Anaerobic medium. The anaerobic medium was obtained by bubbling argon gas through the reaction medium. The reaction medium in most experiments was kept in an airtight container, such as a bottle of penicillin or a syringe. In experiments where it was difficult to work in sealed containers (PCR, restriction enzymes EcoP15I and EcoRI, and T4 DNA Ligase enzyme), the reaction solution was kept under a stream of argon gas during the anaerobic stage.
Production of Cu+ ions in the experimental solution. Prior to enzymatic experiments, Cu+ ions were produced from deaerated aqueous solutions containing a mixture of CuCl2 as the source for Cu2+ ions, metallic copper, and 0.1 M acetonitrile as a stabilizing ligand, according to equation 1:

Injection of copper ion solutions via syringes. Solutions containing Cu+ ions were gently injected through a three-way syringe valve into the anaerobic medium.
Gel electrophoresis was used to separate the DNA fragments based on their size and charge, in order to identify and quantify PCR, Ligase, and restriction enzymes’ activity under various experimental conditions. Quantification was performed by measuring the brightness level of the resulting stripe, and comparing it to the brightness level of a known fragment of a DNA marker (positive/negative control) in the same run.
Figure 1 shows the bacterial population over time after the introduction of 0.4M monovalent copper ions. Those experiments were conducted under anaerobic conditions at Different temperatures ( 20 and 30 degrees Celsius).

Figure 1: E. Coli bacterial population over time after the introduction of 0.4mM monovalent copper ions, under anaerobic conditions, 1% acetonitrile at temperatures of 20 and 30 °C, compared to the control under the same conditions (30 °C) 1% acetonitrile without monovalent copper ions.
We may conclude from the experiments that monovalent copper ions reduce the bacterial population by 5 orders of magnitude in less than 30 seconds. Increasing the temperature increases the effect. An increase of 10 degrees (from 20 °C to 30 °C) reduces the eradication time by a magnitude.
No lysis.
Monitoring the size of the bacterial population using the CFU method compared to a light scattering test (which indicates cell lysis) in bacterial solutions with monovalent copper is shown in Figure 2.

Figure 2: Monitoring E. Coli bacterial population using the CFU method (Triangles) compared to a light scattering test (Round). Black- Cu+ 0.2mM , Blue- Cu+2 0.2mM and Red-control. under anaerobic conditions, 1% acetonitrile at 25 °C.
In the presence of Cu+ ions, there is no correlation between light scattering and the bacterial population; such a correlation exists in the control and in the presence of Cu+2 ions. 10 min from the introduction of Cu+ ions to the solution, no bacterial colony was observed in the CFU method; before the introduction of Cu+ ions, 100,000 bacteria per ml were measured using this method. The absorption at 600nm didn’t change much. On the control and with Cu+2 ions, the CFU method shows an increasing bacterial population with an increase in turbidity. As a whole, dead bacteria still scatter light; the results of the above are consistent with the antibacterial mechanism of the Cu+ ions without lysis of the cell. More than that, examining the action of Cu+ ions on E. Coli bacteria using a light microscope shows that the cells remain intact even though signs of life disappear.
Lidocaine and Marcaine, which regulate the entry of cations into the bacterial cytoplasm, reduce the effect of monovalent copper.
Figure 3 shows experiments in which the effect of sodium channel blockers (lidocaine, Marcaine) on the population of E. Coli and Staphylococcus cohni bacteria in the presence of monovalent copper ions was tested. To obtain a concentration range for work, preliminary tests were performed. For each of the bacteria, concentrations of Marcaine / lidocaine that do not harm the growth of the bacteria were determined. Later, it was determined that the minimum concentration at which Cu+ ions are lethal for the bacteria is 1 mM. The main experiment combines the Cu+ ions with lidocaine/ Marcaine in different molar ratios.

Figure 3: left: Monitoring E. Coli (top) and Staphylococcus cohni (bottom) bacterial population using the CFU method, against different molar ratios of lidocaine/ Cu+ ions, Marcaine/ Cu+ ions.
Right: Photograph of the Petri dishes after seeding and incubation (CFU method), top E. Coli, bottom Staphylococcus cohni, a. Control, b. With 0.1mM Cu+ ions, c. With 0.5mM Marcaine, d. with 0.1mM Cu+ ions and 0.5mM Marcaine, under anaerobic conditions at 25 °C
It was found in the above experiments that, for both types of bacteria, the greater the molar ratio of the Sodium channel blocking / Cu+ concentration, the better the bacteria manage to grow, and the antibacterial activity of Cu+ is masked. It was found that Marcaine suppresses the antibacterial activity of Cu+ on E. Coli and Staphylococcus cohni bacteria more than lidocaine, and E. Coli bacteria are more affected by lidocaine and Marcaine. The results are as expected since gram-negative bacteria contain a simpler membrane array than gram-positive bacteria. Therefore, it is likely that it is easier to block the entry of ions in the former. The conclusions are that Cu+ enters the bacterial cells through sodium channels, and blocking these channels reduces the antibacterial activity of Cu+.
To demonstrate the influence of molecular oxygen on the antibacterial effect of monovalent copper ions, an experiment was performed in a vertical syringe open to the air at the top and connected to a helium gas cylinder at the nozzle (Figure 4, left). Figure 4, right, shows monitoring of the bacterial population in the presence of copper ions, when the helium is flowed through the solution, and when the flow is stopped and oxygen from the air is allowed to dissolve.

Figure 4: Monitoring E. Coli (top) bacterial population using the CFU method in a syringe containing 0.4mM copper sulfate salt, metallic copper, and 1% acetonitrile, with helium flowing through the solution (bubbling), and with the solution exposed to air (stop He flow).
Flowing helium through the solution ensures a reduction in the dissolved oxygen concentration in the water and allows reaction 1 to produce monovalent copper ions that damage the bacterial population. Exposure to air allows oxygen from the air to dissolve and oxidize the monovalent to divalent copper ions, thus allowing the bacterial population to recover. The speed at which the bacterial population recovers indicates that the ROS mechanism is negligible relative to the main mechanism of action.
The study [3] demonstrates the effect of monovalent and divalent copper ions on DNA polymerase, ligase T4 DNA, the restriction enzymes EcoP15I and EcoR I, acid phosphatase, and α and βamylase enzymes. These systems were chosen because they can be monitored under conditions necessary for maintaining a stable concentration of monovalent copper ions, and since they exhibit a wide range of dependency on ATP. Figure 5 presents the influence of copper, silver, nickel, and zinc ions on DNA polymerase (PCR System).

Figure 5: Comparison between the amount of DNA obtained in PCR processes with the addition of Zn+2, Cu+2, and Ni+2 at a concentration of 0.8 µM, Cu+ 0.08 µM relative to the positive control
In this study, we have shown that monovalent copper ions(1*10-7M Cu+) at very low concentrations, and monovalent silver ions (1*10-5M Ag+) at low concentrations, cause complete deactivation of DNA polymerase.
Figure 6 presents the influence of copper, nickel, and zinc ions on acid phosphatas.

Figure 6: Comparison between the amount p-nitrophnol (PNP) obtained from Alkaline Phosphatase enzyme activity with the addition of Zn+2, Cu+2, Ni+2, and Cu+ at a concentration of 8 mM relative to the positive control and spontaneous reaction (without the enzyme)
The results in figure 6 demonstrate the dramatic impact of Cu+ ions on the phosphatase enzyme. To determine the nature of the inhibition, kinetic experiments were performed at several Cu+ ions concentrations (0.1-20mM) (1% CH3CN), under anaerobic conditions A Lineweaver-Burk plot was used for the determination of Vmax and Km; From the Lineweaver-Burk plot and from Vmax (0.17 mM/min) and Km (0.28 mM) values, it is clear that Cu+ ions are non-competitive inhibitors
The results showed that monovalent copper ions dramatically inhibit DNA polymerase and acid phosphatase, inhibit ligase T4 DNA and the restriction enzyme EcoP15I, moderately inhibit α and β amylase, and have no effect on the restriction enzyme EcoR I.
According to the findings presented, several points emerge:
In accordance with the findings detailed in the points mentioned above, we propose a killing mechanism involving the entry of monovalent copper ions into the bacterial Cytoplasm, which causes irreversible enzyme inhibition in the cell.